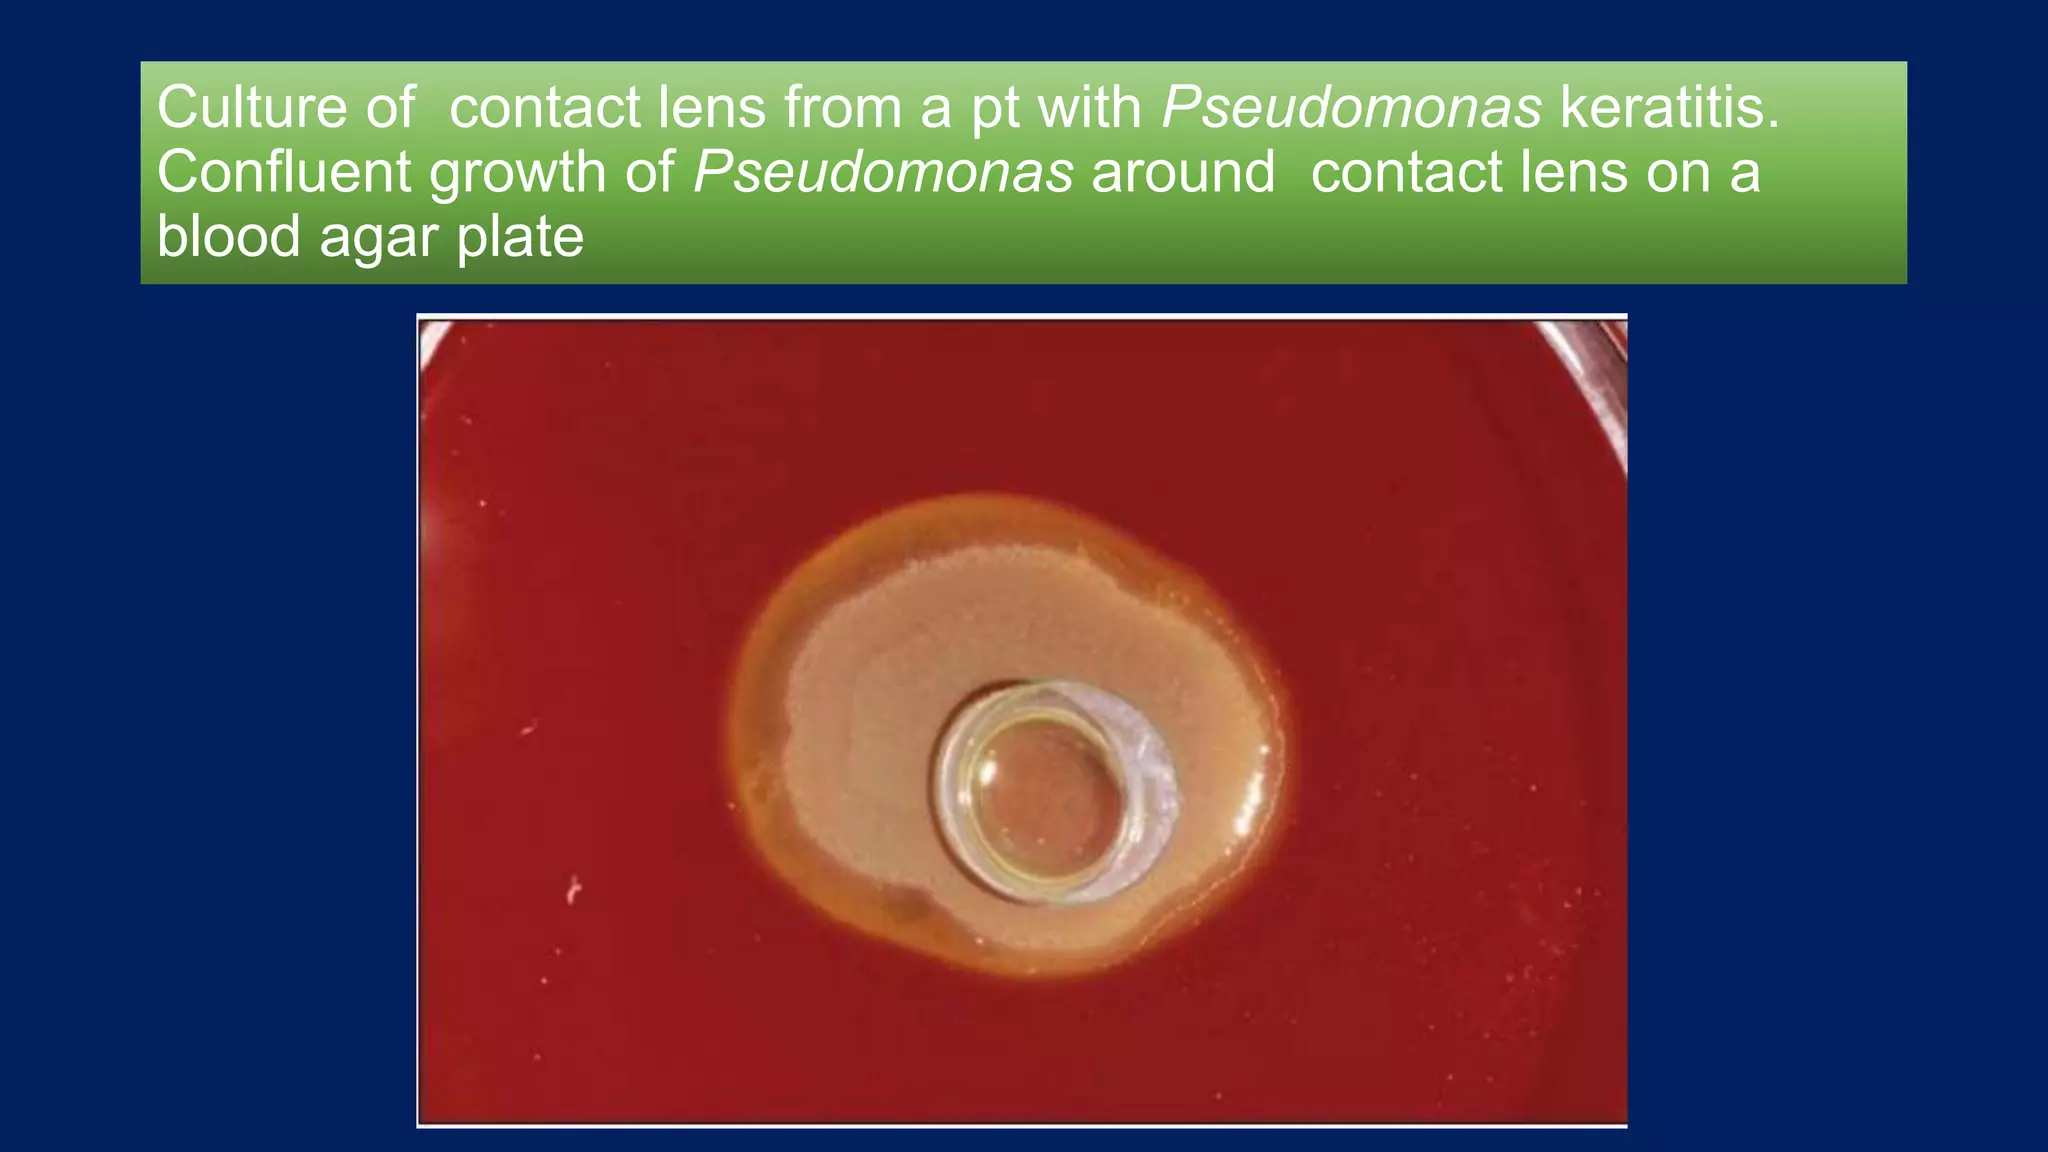
Culture of contact lens from a pt with Pseudomonas keratitis.
Confluent growth of Pseudomonas around contact lens on a
blood agar plate
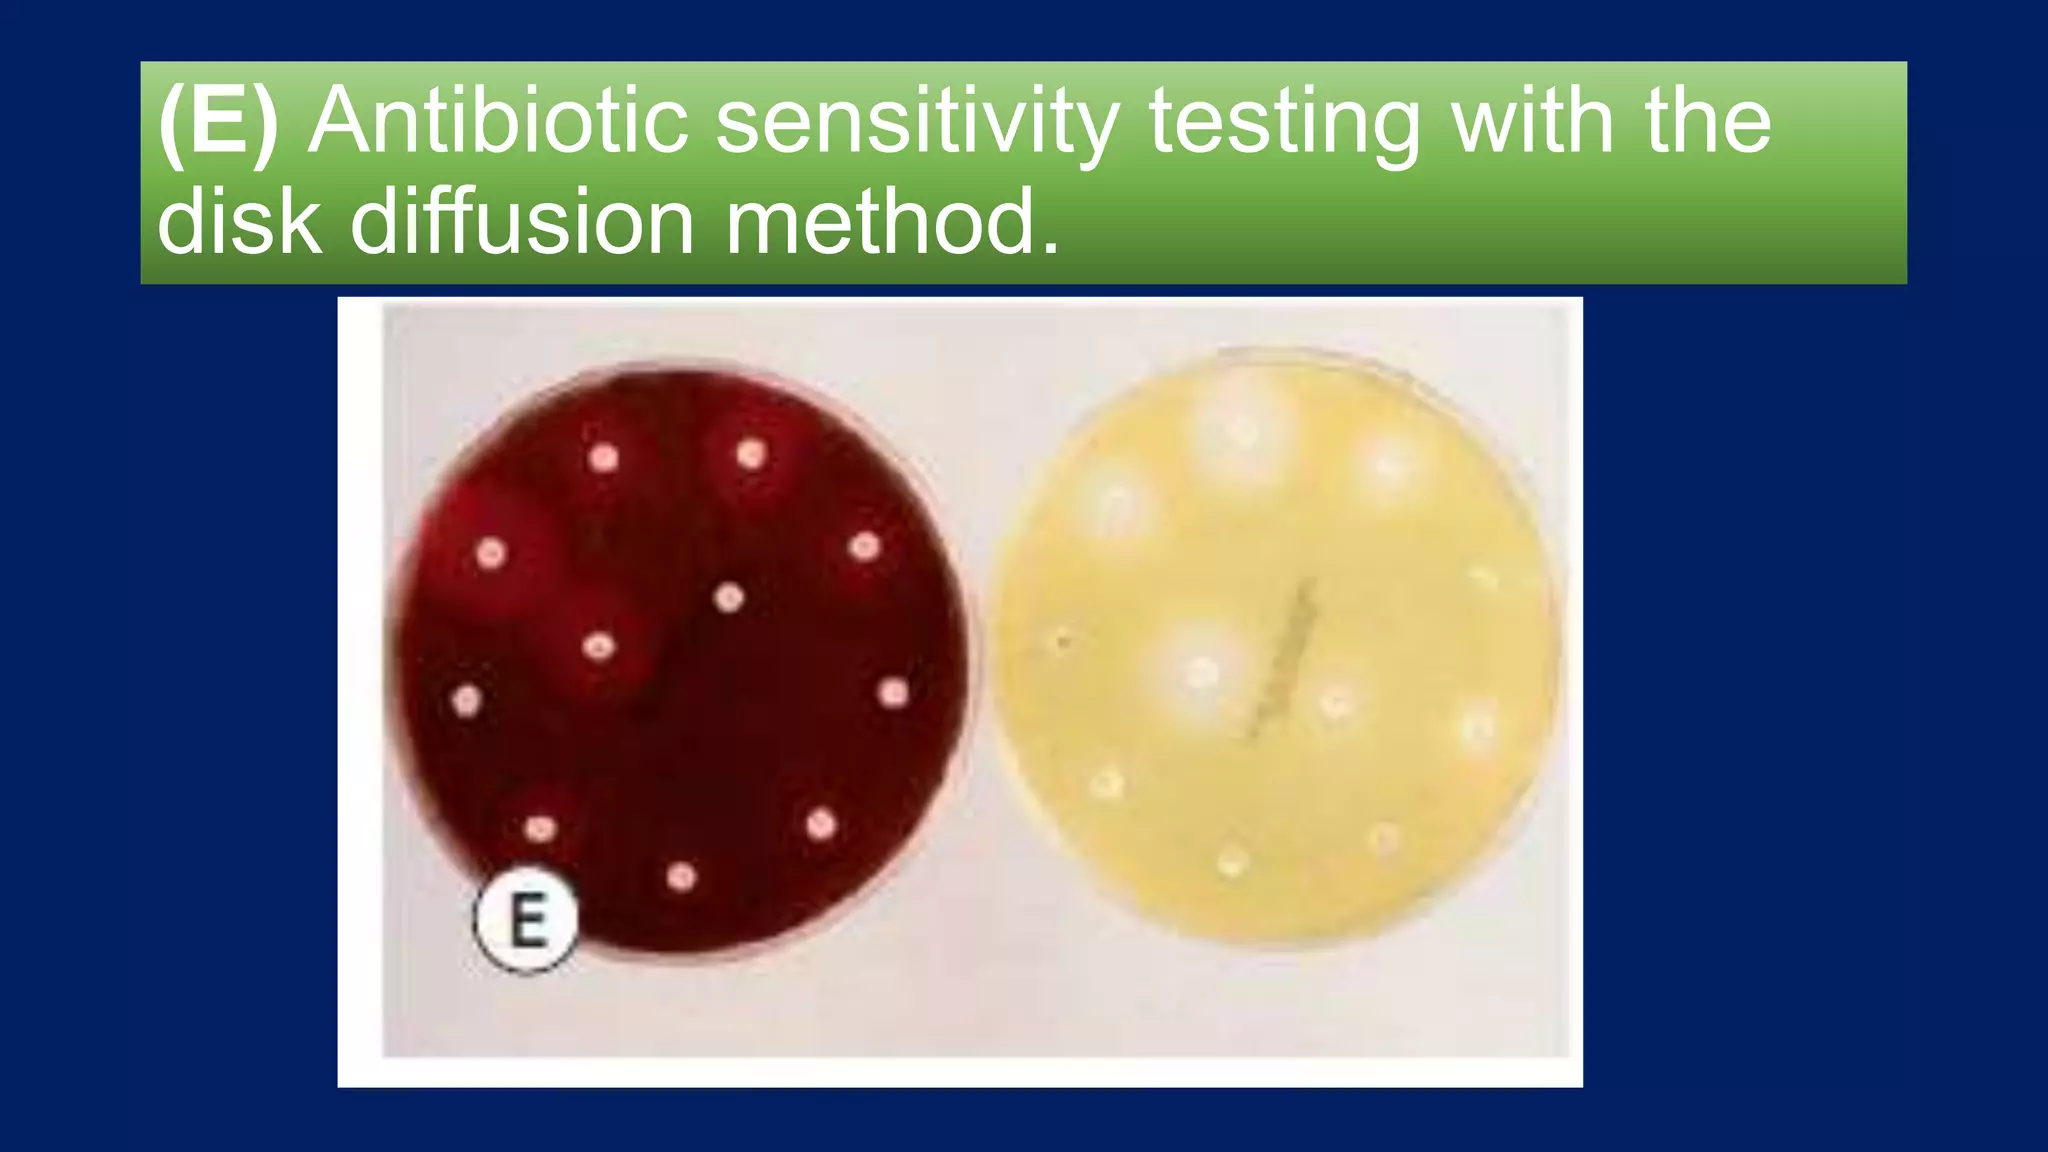
(E) Antibiotic sensitivity testing with the
disk diffusion method.

Bacterial, fungal, viral, and parasitic infections can cause keratitis, which is an inflammation of the cornea. The document discusses the normal flora of the eye and bacteria that can overcome intact epithelium. It describes the presentation of bacterial keratitis and factors that can predispose the eye to infection like contact lens wear or trauma. Diagnosis is based on clinical history, exam findings, and testing corneal scrapings, while treatment involves appropriate antibiotics.

![Introduction
• When there is strong suspicion for a possible infectious
keratitis, laboratory investigations should be considered in order
to identify and confirm the causal organisms. Based on the
clinical and laboratory findings, a therapeutic plan can then be
initiated.[2] It is sometimes necessary to modify the therapeutic
plan based on clinical response and tolerance of the
antimicrobial agents. The goals for treating bacterial keratitis
are to treat the corneal infection and associated inflammation,
and to restore corneal integrity and visual function.](https://image.slidesharecdn.com/keratitis2016-160513173750/75/Keratitis-2016-44-2048.jpg)

![Anti fungal drugs
• Among the azoles, the most commonly used compounds have
been topical voriconazole and oral ketoconazole and
itraconazole. Vemulakonda et al. analyzed the aqueous and
vitreous penetration of topically administered voriconazole 1%
(1 drop every 2 hours for 1 day) in noninflamed human eyes
undergoing planned vitrecomy.[139] The aqueous and vitreous
levels exceeded or met the MIC90 for most pathogens,
demonstrating that voriconazole can be suitable as an
ophthalmic drop. Several clinical case reports have reported on
the successful use of voriconazole on fungal keratitis which
failed to respond to conventional agents.](https://image.slidesharecdn.com/keratitis2016-160513173750/75/Keratitis-2016-177-2048.jpg)

![Anti fungal drugs
• The echinocandins (caspofungin and micafungin) have also been
used in the treatment of fungal keratitis. Topical caspofungin 0.5% in
conjunction with intrastromal voriconazole successfully treated a
patient with Alternaria keratitis. Likewise, micafungin 0.1%, used as
a single agent, successfully treated three patients with Candida
keratitis.[146]
• Several topical antifungal medications may act synergistically
against a particular fungal organism. Amphotericin B 0.15% and
subconjunctival rifampin were more effective than amphotericin
alone. Amphotericin B and flucytosine (5-flurocytosine) have
synergistic effects. Natamycin and ketoconazole have been used
effectively in an animal model of Aspergillus keratitis.](https://image.slidesharecdn.com/keratitis2016-160513173750/75/Keratitis-2016-179-2048.jpg)

![Anti fungal drugs
• Clinically, commercially available natamycin 5% suspension is
the initial drug of choice for fungal keratitis. If worsening of the
keratitis is observed on topical natamycin, topical amphotericin
B 0.15% can be substituted in cases of Candida spp. keratitis
and Apergillus keratitis. An oral or topical azole can be
substituted or added in cases Fusarium spp. keratitis. The
length of time required for topical treatment has not been firmly
established clinically or experimentally. Guidelines have been
derived from retrospective clinical reviews. Jones et al.[135]
reported an average of 30 days of treatment for Fusarium
keratitis with natamycin](https://image.slidesharecdn.com/keratitis2016-160513173750/75/Keratitis-2016-181-2048.jpg)







































































